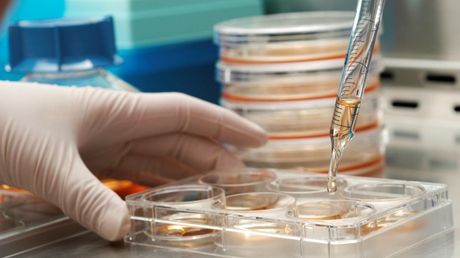
Studii de cercetare/ Arhivă foto

Pas important în lupta cu una dintre cele mai agresive forme de cancer. Inteligența artificială (AI) ar putea depista boala în stadiu incipient
Studii de cercetare/ Arhivă foto
O șansă uriașă în lupta cu cancerul vine dintr-o direcție la care poate că nu ne-am fi așteptat. Vorbim despre o platformă de inteligenţă artificială (IA) dezvoltată de o echipă de cercetători chinezi, care poate ajuta la detectarea cancerului pancreatic, una dintre cele mai agresive forme de cancer, în stadiu incipient pe baza imagisticii cu raze X de înaltă precizie.
PANDA, o metodă „deep learning” dezvoltată de Alibaba's Damo Academy, poate amplifica şi identifica unele caracteristici patologice subtile în imaginile CT simple, dificil de detectat cu ochiul liber, relatează agenţia Xinhua, citată de Agerpres.
Cancerul pancreatic este o tumoare profund malignă, însă are potenţialul de a fi vindecabil dacă este detectat foarte devreme.
Iniţial, instrumentul PANDA a fost antrenat prin utilizarea unui set de date de la un număr de 3.208 pacienţi dintr-un singur centru. Potrivit unui studiu publicat săptămâna aceasta în jurnalul ştiinţific Nature Medicine, instrumentul de inteligenţă artificială a atins o sensibilitate de 94,9% şi o specificitate de 100% în cazul unui grup intern de testare alcătuit din 291 de pacienţi de la Institutul pentru Boli Pancreatice din Shanghai.
Modelul a fost ulterior validat pe grupuri externe formate din persoane de la mai multe centre - în total, 5.337 de pacienţi din China şi din Republica Cehă - pe baza tomografiilor CT abdominale.
Sensibilitatea şi specificitatea sa au fost de 93,3%, respectiv 98,8%, depăşind performanţele unui radiolog mediu, notează Xinhua. Sensibilitatea se referă la capacitatea unui test de a desemna un individ cu boală ca fiind pozitiv, în timp ce specificitatea unui test reprezintă capacitatea sa de a desemna un individ care nu are o boală ca fiind negativ.
Modelul PANDA a fost utilizat în mediul clinic de peste 500.000 de ori, înregistrându-se doar un rezultat fals pozitiv la un număr de o mie de teste. Acesta ar putea deveni un nou instrument pentru screening-ul pe scară largă al cancerului pancreatic, au spus cercetătorii.
Citește și:
- 08:30 - Georgiana Teodorescu, europarlamentar AUR: Ieșim din criză dacă PSD votează moțiunea de cenzură
- 08:14 - Nicușor Dan, discuții cruciale în plină criză la Palatul Cotroceni cu liderii politici. Ce planuri au PSD și AUR
- 08:11 - Un bărbat s-a răsturnat cu mașina în parcarea unui mall din Pitești
- 08:04 - Atac armat la Casa Albă: Trump și Melania, evacuați de urgență de la Cina Corespondenților. Suspectul a fost arestat
Mai multe articole despre
Urmărește știrile Realitatea.NET și pe Google News














